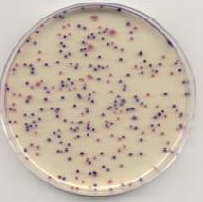
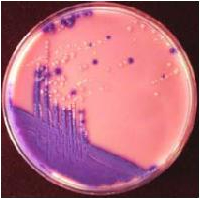

Лабораторное оборудование
Новые ответы на Вечные вопросы
Подписаться на рассылку
Компания СИМАС
Москва, Варшавское шоссе
д.125 стр.1
+7 (495) 980 - 29 - 37,
+7 (916) 942 - 65 - 95
info@simas.ru
Москва, Варшавское шоссе
д.125 стр.1
+7 (495) 980 - 29 - 37,
+7 (916) 942 - 65 - 95
info@simas.ru

Компания СИМАС приглашает Вас посетить наш стенд № 123 А на выставке Интерлабдиагностика – 2009
25.09.2009
.jpg)
Уважаемые коллеги ! Компания СИМАС приглашает Вас посетить наш стенд № 123 А на выставке Интерлабдиагностика – 2009, лабораторное обеспечение медицинской помощи, которая будет проходить 28 – 30 сентября 2009 г. в Научно-исследовательском центре ММА им. И.М. Сеченова (Москва, ул. Трубецкая, д. 8).
Мы можем предоставить Вам бесплатные пригласительные билеты.
Заказать. Будем рады видеть Вас на нашем стенде : № 123 А
Медицинским лабораториям компания СИМАС может предложить уникальную продукцию производства OXOID и Whatman:
- Экспресс-тест для диагностики и дифференцирования вирусов гриппов А (H1N1) и В
- Тест-системы для экспресс диагностики диарей
- Жидкие и сухие латексные тест - системы для быстрой идентификации бактерий
- Наборы для определения энтеро-токсинов
- Планшетные и стриповые системы Microbact для биохимической видовой идентификации микроорганизмов
- Агглютинируюшие сыворотки и диагностикумы для экспресс-идентификации бактерий
- Окрашенные диагностикумы для выявления, идентификации и полуколичественного определения антител в сыворотке крови больных
- Определение чувствительности к антибиотикам (диски с антибиотиками, диагностические диски, распределитель (диспенсер) дисков с антибиотиками)
- ДИП-слайды для бактериологической диагностики инфекций мочевыводящих путей
- Хромогенные питательные среды для клинической микробиологии
- Бумагу 903 для диагностики заболеваний новорожденных
Продукция для лабораторий (откроется в новом окне)




Хромогенный агар CM 0956
для кишечной палочки и колиформных бактерий.
Хромогенный агар CM 1050
для основных возбудителей инфекций мочевыводящих путей.
.jpg)
Уважаемые коллеги ! Компания СИМАС приглашает Вас посетить наш стенд № 123 А на выставке Интерлабдиагностика – 2009, лабораторное обеспечение медицинской помощи, которая будет проходить 28 – 30 сентября 2009 г. в Научно-исследовательском центре ММА им. И.М. Сеченова (Москва, ул. Трубецкая, д. 8).
Мы можем предоставить Вам бесплатные пригласительные билеты.
Заказать. Будем рады видеть Вас на нашем стенде : № 123 А
Медицинским лабораториям компания СИМАС может предложить уникальную продукцию производства OXOID и Whatman:
- Экспресс-тест для диагностики и дифференцирования вирусов гриппов А (H1N1) и В
- Тест-системы для экспресс диагностики диарей
- Жидкие и сухие латексные тест - системы для быстрой идентификации бактерий
- Наборы для определения энтеро-токсинов
- Планшетные и стриповые системы Microbact для биохимической видовой идентификации микроорганизмов
- Агглютинируюшие сыворотки и диагностикумы для экспресс-идентификации бактерий
- Окрашенные диагностикумы для выявления, идентификации и полуколичественного определения антител в сыворотке крови больных
- Определение чувствительности к антибиотикам (диски с антибиотиками, диагностические диски, распределитель (диспенсер) дисков с антибиотиками)
- ДИП-слайды для бактериологической диагностики инфекций мочевыводящих путей
- Хромогенные питательные среды для клинической микробиологии
- Бумагу 903 для диагностики заболеваний новорожденных
Продукция для лабораторий (откроется в новом окне)

Хромогенный агар CM 0956
для кишечной палочки и колиформных бактерий.
Хромогенный агар CM 1050
для основных возбудителей инфекций мочевыводящих путей.
















































